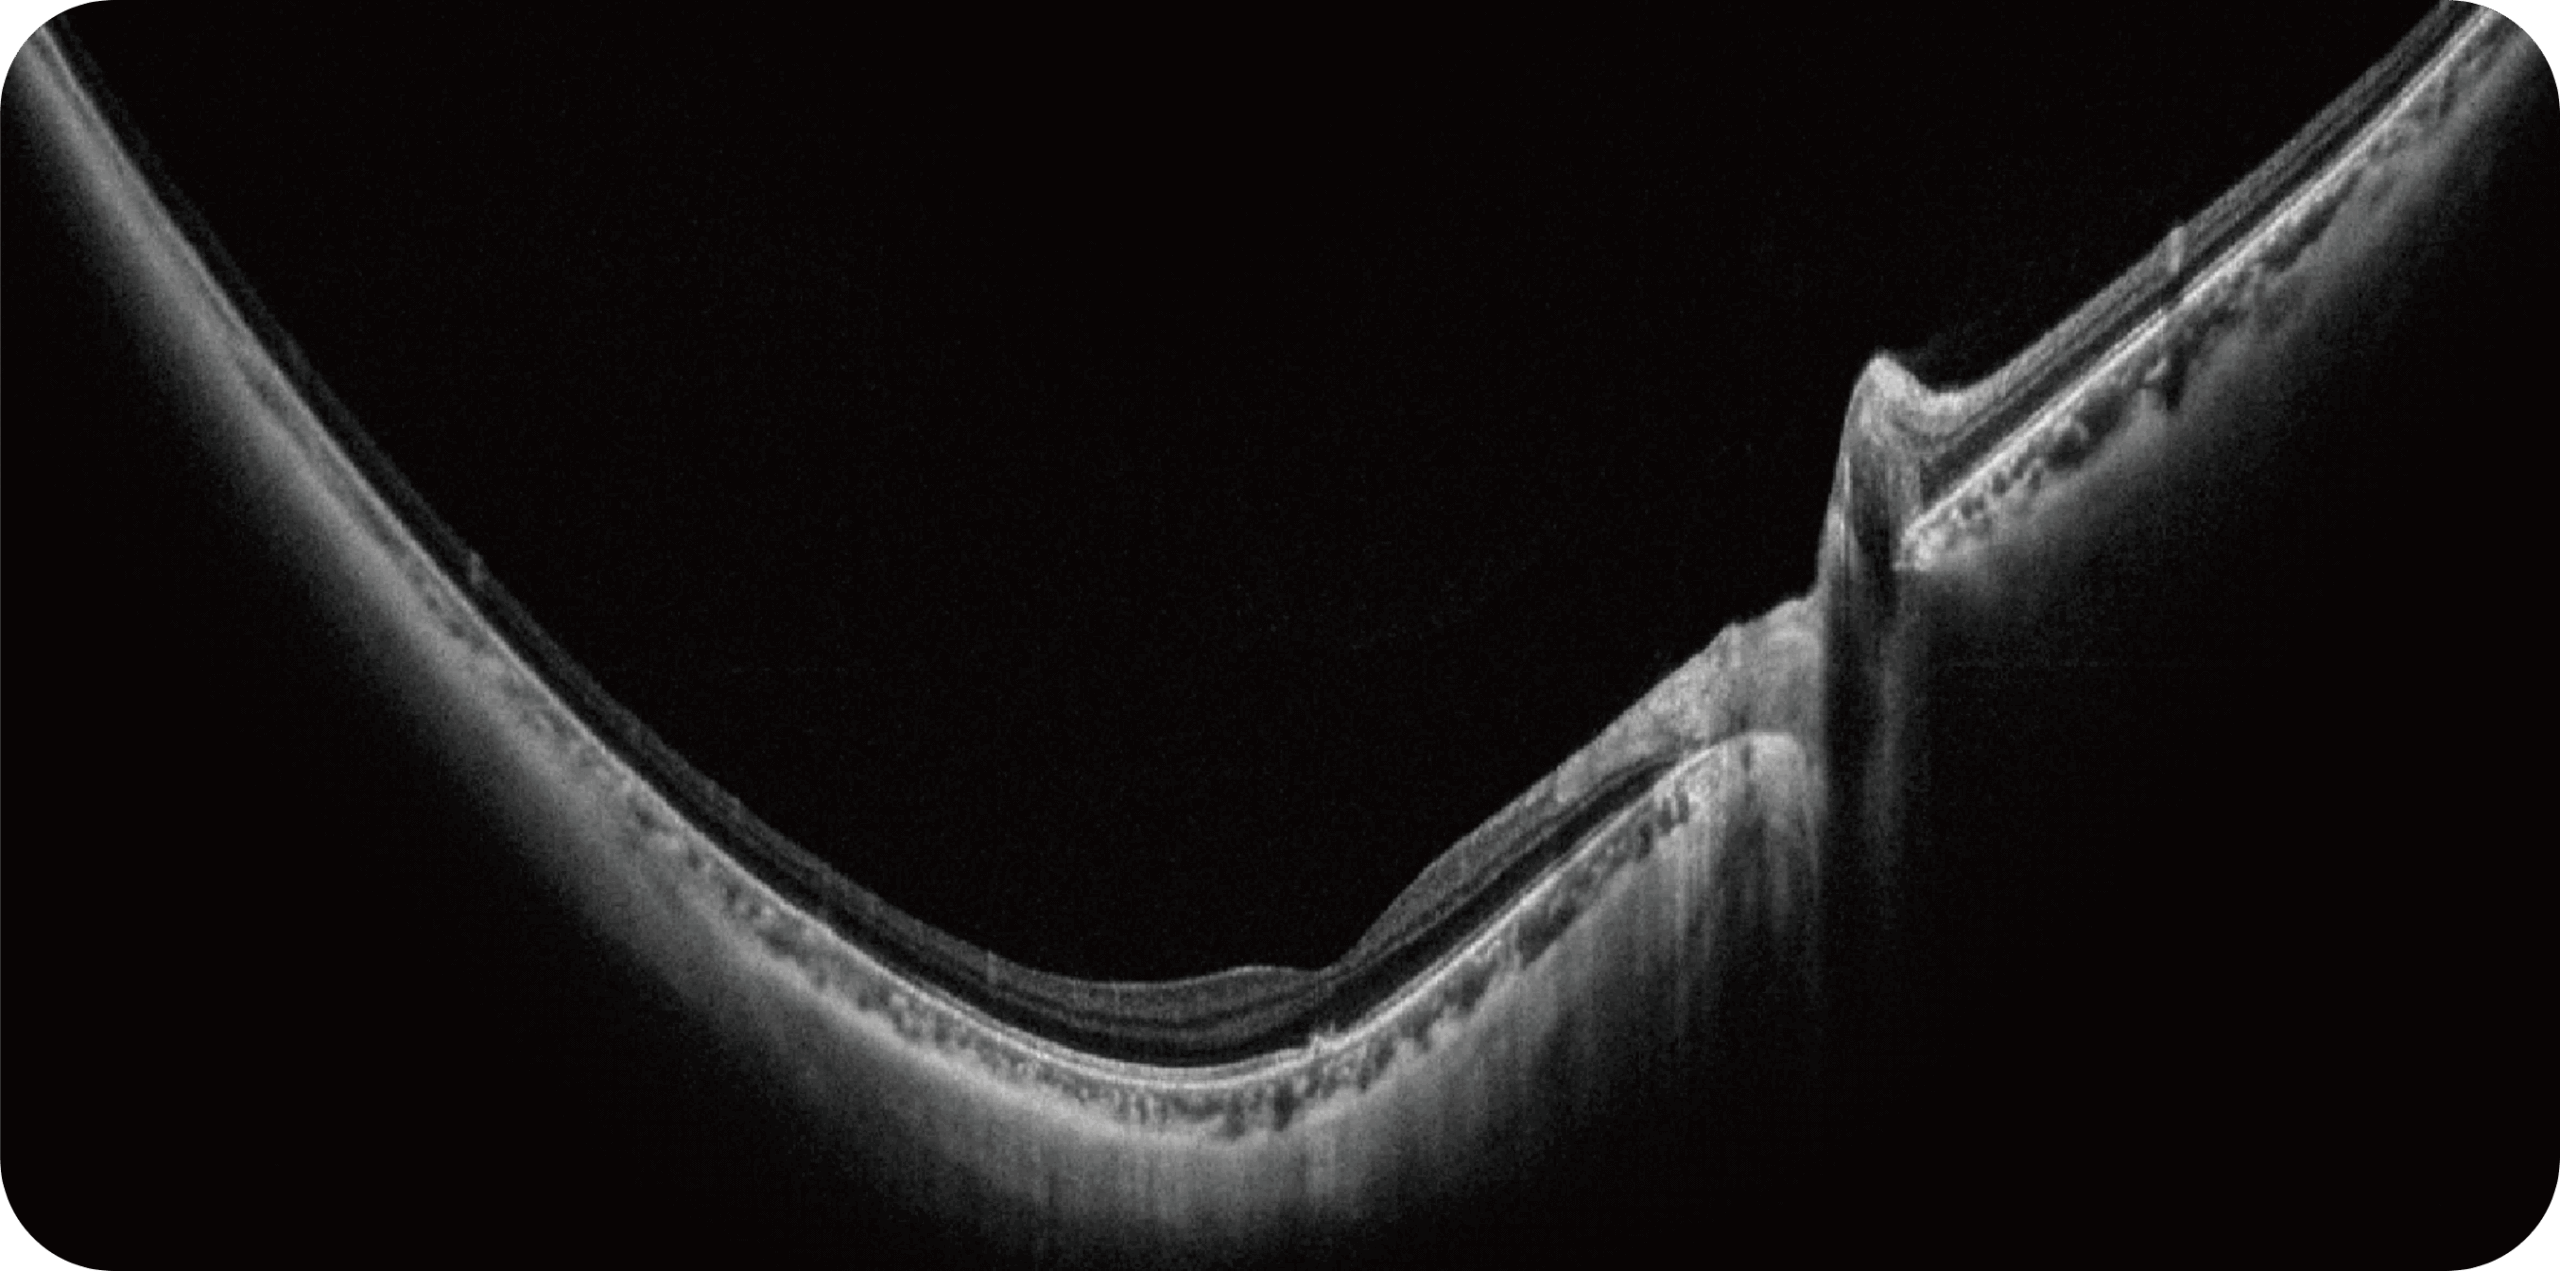

SKY
OCT MULTIMODAL UWF
e OCT swept-source em um único exame, com captura síncrona,
alta velocidade e máxima definição.
SKY OCT MULTIMODAL UWF
Tecnologia multimodal para diagnóstico de última geração
Por que escolher
o SKY OCT Multimodal UWF?
Olho Inteiro
Uma única varredura pode obter rapidamente imagens sincronizadas de imagens coloridas de campo ultralargo/FAF/FFA/ICGA e SS-OCT, alcançando sincronização em tempo real e alinhamento preciso de imagens planas e estruturais da retina, melhorando significativamente a eficiência da inspeção e otimizando o processo de diagnóstico e tratamento.” Uma única varredura pode obter rapidamente imagens sincronizadas de imagens coloridas de campo ultralargo/FAF/FFA/ICGA e SS-OCT, alcançando sincronização em tempo real e alinhamento preciso de imagens planas e estruturais da retina, melhorando significativamente a eficiência da inspeção e otimizando o processo de diagnóstico e tratamento.
Multi-Modalidade
Altamente integrado com tecnologias como SLO confocal e SS-OCT, ele combina imagens coloridas SLO de campo ultralargo, angiografia confocal a laser, autofluorescência e imagens tomográficas de segmento anterior e posterior ultraamplas e profundas em um único sistema.
O SKY OCT é indicado para:
Retinopatia diabética, degeneração macular e outras doenças da retina.
Estudo da coroide em casos complexos.
Exames de segmento anterior com OCT de 28mm.
Angiografia multimodal (FA e ICG – disponível nas versões avançadas).
OCTA até 220° em mosaico, para análise detalhada da vascularização.
O que nossos clientes dizem sobre a Suplimed
Médicos de diversas regiões já compartilham como a Suplimed tem elevado a qualidade do atendimento e os resultados clínicos.
Diagnóstico completo em um único exame!
O SKY OCT Multimodal UWF da Micro Clear redefine o padrão de exames de retina e segmento anterior, unindo velocidade, profundidade e campo ultrawide em uma solução única. Ideal para clínicas e centros de referência que buscam precisão, agilidade e inovação no diagnóstico oftalmológico.